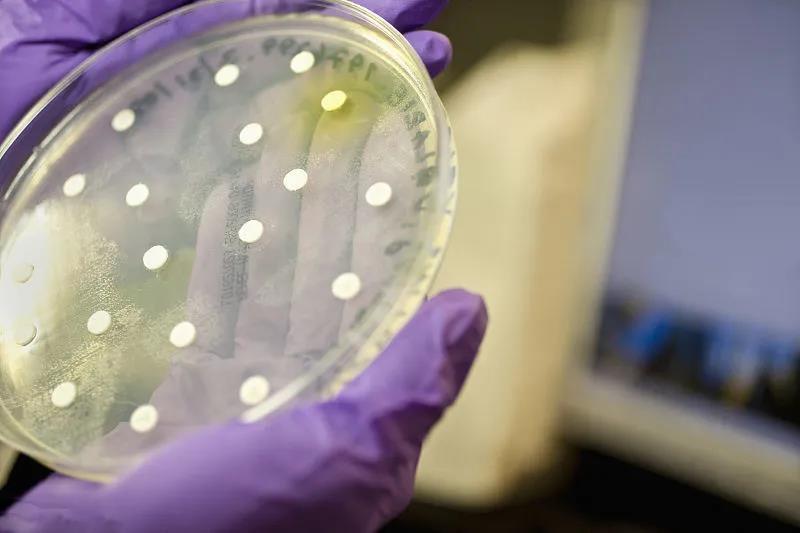

今天,下面小編就帶大家一起來詳細的了解下微生物中的菌落總數(shù)和大腸菌群。

一、微生物
主要包括:細菌、病毒、真菌以及一些小型的原生生物、顯微藻類等在內(nèi)的一大類生物群體,它個體微小,與人類關(guān)系密切。
二、菌落總數(shù)
食品檢樣經(jīng)過處理,在一定條件下(如培養(yǎng)基、培養(yǎng)溫度和培養(yǎng)時間等)培養(yǎng)后,所得每g(ml)檢樣中形成的微生物菌落總數(shù)。
1、菌落總數(shù)的測定
用來判定食品被細菌污染的程度及衛(wèi)生質(zhì)量,它反應(yīng)食品在生產(chǎn)過程中是否符合衛(wèi)生要求,以便對被檢樣品做出適當(dāng)?shù)男l(wèi)生學(xué)評價。菌落總數(shù)的多少在一定程度上標(biāo)志著食品衛(wèi)生質(zhì)量的優(yōu)劣。
2、菌落總數(shù)超標(biāo)的原因
(1)生產(chǎn)企業(yè)所使用的原輔料初始菌數(shù)較高,又未按要求嚴(yán)格控制生產(chǎn)加工過程的衛(wèi)生條件。
(2)包裝容器清洗消毒不到位。
(3)與產(chǎn)品包裝密封不嚴(yán)、儲運條件控制不當(dāng)?shù)扔嘘P(guān)。
3、菌落總數(shù)超標(biāo)的危害
消費者食用微生物超標(biāo)嚴(yán)重的食品,很容易患痢疾等腸道疾病,可能引起嘔吐、腹瀉等癥狀,危害人體健康安全。
但需要強調(diào)的是,菌落總數(shù)和致病菌有本質(zhì)區(qū)別,菌落總數(shù)包括致病菌和有益菌,對人體有損害的主要是其中的致病菌,這些病菌會破壞腸道里正常的菌落環(huán)境,一部分可能在腸道被殺滅,一部分會留在身體里引起腹瀉、損傷肝臟等身體器官,而有益菌包括酸奶中常被提起的乳酸菌等。但菌落總數(shù)超標(biāo)也意味著致病菌超標(biāo)的機會增大,增加危害人體健康的幾率。
三、大腸菌群
主要來源于人畜糞便,是以糞便污染指標(biāo)來評價食品的衛(wèi)生質(zhì)量,推斷食品中有否污染腸道致病菌的可能。
1、大腸菌群分布較廣,在溫血動物糞便和自然界廣泛存在。
調(diào)查研究表明,大腸菌群細菌多存在于溫血動物糞便、人類經(jīng)常活動的場所以及有糞便污染的地方,人、畜糞便對外界環(huán)境的污染是大腸菌群在自然界存在的主要原因。糞便中多以典型大腸桿菌為主,而外界環(huán)境中則以大腸菌群其他型別較多。
2、大腸菌群是以該菌群的檢出情況來表示食品中有否糞便污染。
大腸菌群的高低,表明了糞便污染的程度,也反映了對人體健康危害性的大小。糞便是人類腸道排泄物,其中有健康人糞便,也有腸道患者或帶菌者的糞便,所以糞便內(nèi)除一般正常細菌外,同時也會有一些腸道致病菌存在(如沙門氏菌、志賀氏菌等),因而食品中有糞便污染,則可以推測該食品中存在著腸道致病菌污染的可能性,潛伏著食物中毒和流行病的威脅,必須看作對人體健康具有潛在的危險性。

3、大腸菌群超標(biāo)的危害
據(jù)分析,造成食品中的大腸菌群超標(biāo)的主要原因是二次污染,大腸菌群數(shù)的高低,表明了糞便污染的程度,也反映了對人體健康危害性的大小,所以導(dǎo)致大腸菌群超標(biāo)的主要原因是二次污染。如加工器具沒有定期清洗消毒,操作人員在上完衛(wèi)生間后洗手不徹底,個人衛(wèi)生狀況未達標(biāo),直接影響最終產(chǎn)品的衛(wèi)生狀況。
食品中大腸菌群超標(biāo)會破壞其營養(yǎng)成分,加快食品腐敗變質(zhì)的速度,降低食物營養(yǎng)價值。食用大腸菌群超標(biāo)的食物易引起腸道疾病,特別是導(dǎo)致腸胃感染、腹瀉嘔吐、嚴(yán)重威脅健康安全。








當(dāng)前所在頁面:















